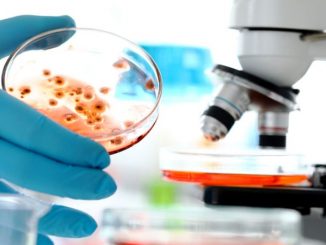

Research discovery may help diagnose and treat cancer and brain disorders
Researchers at Queen’s University Belfast have revealed how the pathway of an identified protein could lead to early diagnosis and […]
Researchers at Queen’s University Belfast have revealed how the pathway of an identified protein could lead to early diagnosis and […] Knowing the structure of a complex biological system isn't nearly enough to understand how it works. It helps to know […] Taking notes from blockbusters such as Outbreak and World War Z, viruses are typically seen as harmful agents to be […] Within weeks, updated COVID-19 vaccines could become available across the United States, offering protection against new variants of coronavirus that […] A possible way to tackle one of the underlying causes of asthma has been developed by researchers from Aston University […] Smokers for whom annual screening with low-dose computed tomography (LDCT) is not recommended may have a high risk for lung […] New insights into the role that small molecules called microRNAs play in human skin wound healing have been published today […] Most people in the United States have some degree of immune protection against COVID-19, either from vaccination, infection, or a […] Researchers are seeking thousands of volunteers in the U.S. and Europe to test the first potential vaccine against Lyme disease […] Everyone feels tired sometimes. But how do you know whether your tiredness is a problem worth seeing a doctor about? […]Health News

Research discovery may help diagnose and treat cancer and brain disorders

Rice University researchers model a key mechanism by which DNA replicates
Scientists Identify Viruses as New Weapons to Fight IBD

Most older adults ready to roll up sleeves this fall for updated COVID-19 boosters

Potential long-term treatment for asthma found

Lung cancer risk increased for smokers not offered annual screening

Study identifies potential targets for treating venous ulcers

New test may predict COVID immunity

Major test of first possible Lyme vaccine in 20 years begins

Why am I so tired and when is it time to see the doctor about it? A GP explains
Copyright © 2026